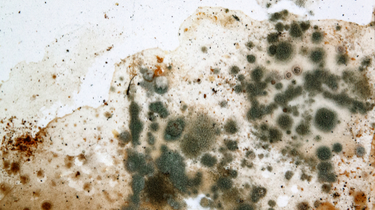

What to Expect During a Mold Inspection
Learn exactly what happens during a professional mold inspection — from the initial walkthrough to lab results — and why the inspector's expertise matters more than the tools.

Mold & Homeowner's Insurance: Is Remediation Covered?
Most homeowner's insurance policies exclude or severely limit mold coverage. Learn what is and isn't covered, how coverage varies by state, and how to protect yourself.

ERMI Mold Testing: Advanced Mold Detection for Health-Sensitive Environments
Learn how ERMI testing from MI&T uses EPA-developed DNA technology to identify mold exposure linked to health issues. Trusted nationwide mold testing specialists.

Bedroom Mold Growth and Odors; What You Need to Know
Learn how to identify, prevent, and eliminate bedroom mold growth and odor. Understand the health risks, causes, and effective solutions to maintain a clean, safe, and odor-free sleeping environment.

Boat Mold Growth: Causes, Remediation, and Prevention
Discover why mold thrives on boats, how to remove it effectively, and key prevention strategies to keep commercial and personal vessels mold-free.

Ductwork Mold Problems in Commercial and Residential Properties: Causes, Remediation, and Prevention
Learn how mold develops in ductwork, its impact on indoor air quality, and effective remediation and prevention strategies for commercial and residential properties.

Garage Mold Growth and Odor: Causes, Remediation, and Prevention
Discover the causes of garage mold growth and musty odors, effective remediation methods, and expert tips for prevention. Keep your garage mold-free and fresh!

Laundry Room Mold Growth and Odor: Causes, Remediation, and Prevention
Uncover why mold and musty odors thrive in laundry rooms, how to eliminate them effectively, and the best strategies to prevent future growth for a cleaner, healthier home.

Mold Problems in Office Spaces: Causes, Inspection, Remediation, and Prevention
Learn about the causes of mold in office spaces, how to inspect for growth, effective remediation methods, and prevention strategies to maintain a healthy workplace.

Refrigeration Unit Mold Problems: Causes, Remediation, and Prevention
Discover the causes of mold in commercial refrigeration units, effective remediation methods, and key prevention strategies to ensure a clean and sanitary environment.

Window Mold Growth Problems: Causes, Remediation, and Prevention
Window Mold Growth Problems: Causes, Remediation, and Prevention Mold growth around windows is a persistent problem for both residential and commercial buildings. Windows, which are exposed to fluc...

Ceiling Mold Growth: Causes, Remediation, and Prevention
Indoor mold growth can be very concerning, especially to those that are more susceptible to the negative health effects of mold. If you have found yourself on this page, it is likely you are seeing something abnormal on one or more of your ceilings. We’ve compiled this article to educate people on everything regarding ceiling mold growth.

Mold in the Kitchen: Causes, Detection, and Prevention
Mold in the kitchen can affect your health and home. Learn about the causes, how to detect mold, and effective ways to prevent it from taking hold.

What Causes Mold On Walls and How To Prevent It?
Worried about mold growth at home? Learn what causes mold on walls and its prevention in this guide!

Can Mold Make You Dizzy?
Let’s discover if mold can cause dizziness and learn effective tips to prevent mold exposure to keep you safe.
What is Mold?
Mold is a type of fungus that grows in damp environments. Learn how it develops, the risks it poses to your health, and how to prevent it from taking over your home.

15 Common Places to Check for Mold Hiding in Your Home
Mold can hide in unexpected places. Learn where to check for hidden mold and how to prevent it from affecting your indoor air quality.

How Much does a Mold Inspection Cost?
How Much does a mold inspection cost? See pricing and procedures of nationwide Mold Inspection company MI&T here.

White Mold
What is White Mold and is it Dangerous? MI&T is the largest mold inspection only company in the United States, offering over 40 major metropolitan areas mold testing without a conflict of interest.

How to Prevent Indoor Mold Growth
Mold thrives in damp, dark places. Learn the best ways to prevent mold growth in your home, from controlling humidity to improving ventilation.

Do I Need a HEPA Vacuum for My Home
Do I Need a HEPA Vacuum for My Home Vacuuming around your home is an essential part of keeping things clean. The machine removes the dirt and dust from floors, carpets, rugs, and upholstery on the ...

Air Purifier or Humidifier: Which One Should You Use?
Confused between an air purifier and a humidifier? Discover the differences and learn which one is right for improving your indoor air quality and overall health.

Should You Invest in an Air Purifier if you Have Children? What Type of Air Purifier is the Best?
Is an air purifier a good investment for families with children? Learn how to choose the best air purifier to protect your little ones from allergens and pollutants.

Which Whole House Air Purifier Should I Choose?
Which Whole House Air Purifier Should I Choose? If you want to improve the air quality of a single room in your home, a portable air purifier will do just fine; however, if you are looking to clean...

Are Ionizer Air Purifiers Bad for My Health?
Are ionizer air purifiers safe? Get the facts about potential health risks and benefits to determine if an ionizer is right for your home.

Dehumidifiers: What Do They Do and What are the Benefits for Your Home?
Learn how dehumidifiers work to control indoor humidity and prevent mold growth, dust mites, and other allergens in your home.

Have Mysterious Odors In Your Home? How to Identify the Source of Those Strange Smells
Strange smells can signal underlying problems like mold or poor air quality. Learn how to identify the source and address any potential health risks.

What are Winter Allergies and How Can You Avoid Them?
Winter allergies are more common than you think. Learn what triggers them and how to avoid allergens during the colder months.

Do I Need an Air Purifier for My Home or Office?
Do I Need an Air Purifier for My Home or Office?. MI&T is the largest mold inspection only company in the United States, offering over 40 major metropolitan areas mold testing without a conflict of interest.

Can Home Cleaning Products Be Bad For My Health? – What are VOCs?
Some home cleaning products release VOCs that can harm your health. Discover how VOCs in cleaning supplies affect indoor air quality and how to choose safer alternatives.

Will a HEPA Filter Prevent Mold Growth in the Home?
Will a HEPA Filter Prevent Mold Growth in the Home? Are you thinking about getting an air purifier for your home or office? There's a lot to consider when purchasing a prospective machine. Read...

Which Air Purifying Systems are Ozone Free? – Comparing HEPA, Ionizers and UV-C
Which Air Purifying Systems are Ozone Free? – Comparing HEPA, Ionizers and UV-C Ozone is one of the chemically reactive natural gasses found in the stratosphere. Ozone plays an important role...

Why Are More People Developing Allergies Every Year?
Why Are More People Developing Allergies Every Year? Do you have allergies? Does it seem like you're meeting more people with allergies each year? What role does the environment play in develop...

Should I Buy an Air Purifier from Costco, Walmart, or Home Depot?
Wondering where to buy an air purifier? This article compares top retailers like Costco, Walmart, and Home Depot to help you make an informed decision.

Why Do My Allergies Get Worse at Nighttime?
Why Do My Allergies Get Worse at Nighttime? Do you live with the effects of allergies in your life? It's challenging for people with allergies to maintain a normal sense of well-being, especial...

A Guide to Indoor Air Quality Testing: What You Need to Know
Wondering about indoor air quality testing? This guide explains how it works, what pollutants to test for, and how to improve the air quality in your home or office.

Are Ozone Generators Effective At Removing or Controlling Odors?
Ozone generators claim to remove odors, but do they work? Learn the pros and cons of using ozone generators to control indoor air quality and odors.

Dust: Where Does It Come From and How to Control It?
Dust: Where Does It Come From and How to Control It?. MI&T is the largest mold inspection only company in the United States, offering over 40 major metropolitan areas mold testing without a conflict of interest.

Are Volatile Organic Compounds (VOCs) Bad for Your Health?
VOCs are harmful chemicals found in many household products. Learn how VOCs affect your health and steps you can take to reduce exposure in your home.

What are the Causes of My Respiratory Allergies?
Explore the primary causes of respiratory allergies, from airborne pollutants to pet dander, and how to manage them for better health and comfort.

Can You Get Rid of Pet Odors with an Air Purifier?
Air purifiers can help with pet odors. Find out which air purifiers are best for eliminating pet smells and improving the overall air quality in your home.

Do Dust Mite Covers and Hypoallergenic Bedding Help with Dust Mite Allergies?
Dust mite allergies can be troublesome. Find out how dust mite covers and hypoallergenic bedding can help alleviate symptoms and improve your sleep.

What Is Formaldehyde and Why Is It In Your Home?
Formaldehyde is a common indoor pollutant found in furniture, flooring, and building materials. Discover the risks of formaldehyde exposure and how to reduce it in your home.

How to Make the Most of a HEPA Filter
How to Make the Most of a HEPA Filter Manufacturers of HEPA filters claim that their products can remove all types of airborne particles, such as dust, dander, pollen, and even mold and mildew spor...

Should You Test Your Home for Mold After Flooding?
Flooding can lead to hidden mold growth. This article explains why it’s crucial to test for mold after water damage and how to prevent long-term issues.

How Does Relative Humidity Affect Indoor Air Quality?
Relative humidity plays a key role in indoor air quality. Find out how humidity levels affect mold growth, dust mites, and overall comfort in your home.

Does My New Mattress Release VOCs?
New mattresses can off-gas harmful VOCs. Learn how these chemicals can affect your health and what you can do to reduce exposure when purchasing a new mattress.

How Do I Remove Mold from My Home?
Mold removal can be tricky. This article offers practical steps and tips on safely removing mold from your home and preventing it from coming back.

How Can I Remove Smoke from My Home?
Cigarette and other smoke odors can linger in your home. Learn effective methods to remove smoke from your home and improve indoor air quality.

Can A Humidifier Help Me Manage My Allergies
Humidifiers can alleviate allergy symptoms by maintaining optimal moisture levels. Find out how a humidifier can help manage your allergies.

